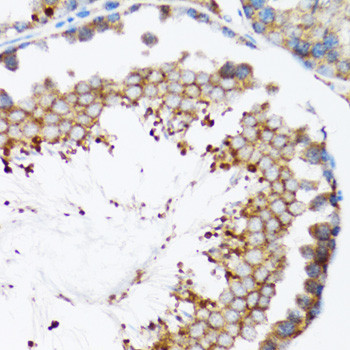
HYOU1 Antibody in Immunohistochemistry (Paraffin) (IHC (P))

Search
Invitrogen
HYOU1 Polyclonal Antibody
{{$productOrderCtrl.translations['antibody.pdp.commerceCard.promotion.promotions']}}
{{$productOrderCtrl.translations['antibody.pdp.commerceCard.promotion.viewpromo']}}
{{$productOrderCtrl.translations['antibody.pdp.commerceCard.promotion.promocode']}}: {{promo.promoCode}} {{promo.promoTitle}} {{promo.promoDescription}}. {{$productOrderCtrl.translations['antibody.pdp.commerceCard.promotion.learnmore']}}
图: 1 / 4
HYOU1 Antibody (PA5-76966) in IHC (P)




Please note: We are reviewing Western blot images included in the antibody testing data in our catalog, including those provided by third parties. Unless expressly labeled or annotated as “raw-unedited”, Western blot images included in the antibody testing data in our catalog may have been edited, optimized or otherwise adjusted for presentation.
产品信息
PA5-76966
种属反应
宿主/亚型
分类
类型
抗原
偶联物
形式
浓度
规格
纯化类型
保存液
内含物
保存条件
运输条件
RRID
产品详细信息
The antibody was affinity-purified from rabbit antiserum by affinity-chromatography using epitope-specific immunogen and the purity is > 95% (by SDS-PAGE).
靶标信息
HYOU1 belongs to the heat shock protein 70 family. The protein is thought to play an important role in protein folding and secretion in the ER. Since suppression of the protein is associated with accelerated apoptosis, it is also suggested to have an important cytoprotective role in hypoxia-induced cellular perturbation. This protein has been shown to be up-regulated in tumors, especially in breast tumors, and thus it is associated with tumor invasiveness. This signal peptide-lacking protein, which is only 3 amino acids shorter than the mature protein in the ER, is thought to have a housekeeping function in the cytosol. In rat, this protein localizes to both the ER by a carboxy-terminal peptide sequence and to mitochondria by an amino-terminal targeting signal.
仅用于科研。不用于诊断过程。未经明确授权不得转售。
篇参考文献 (0)
生物信息学
蛋白别名: 140 kDa Ca(2+)-binding protein; 150 kDa oxygen-regulated protein; 150-kDa oxygen regulated protein; 170 kDa glucose regulated protein GRP170; 170 kDa glucose-regulated protein; calcium binding protein 140; calcium binding protein, 140 kDa; CBP-140; DKFZp686N08236; FLJ94899; FLJ97572; Grp 170; GRP-170; Heat shock protein family H member 4; HSP 12A; Hypoxia up-regulated protein 1; Orp 150; ORP-150
基因别名: AI415631; Cab140; CBP-140; GRP170; HSPH4; HYOU1; ORP150
UniProt ID: (Mouse) Q9JKR6
Entrez Gene ID: (Mouse) 12282